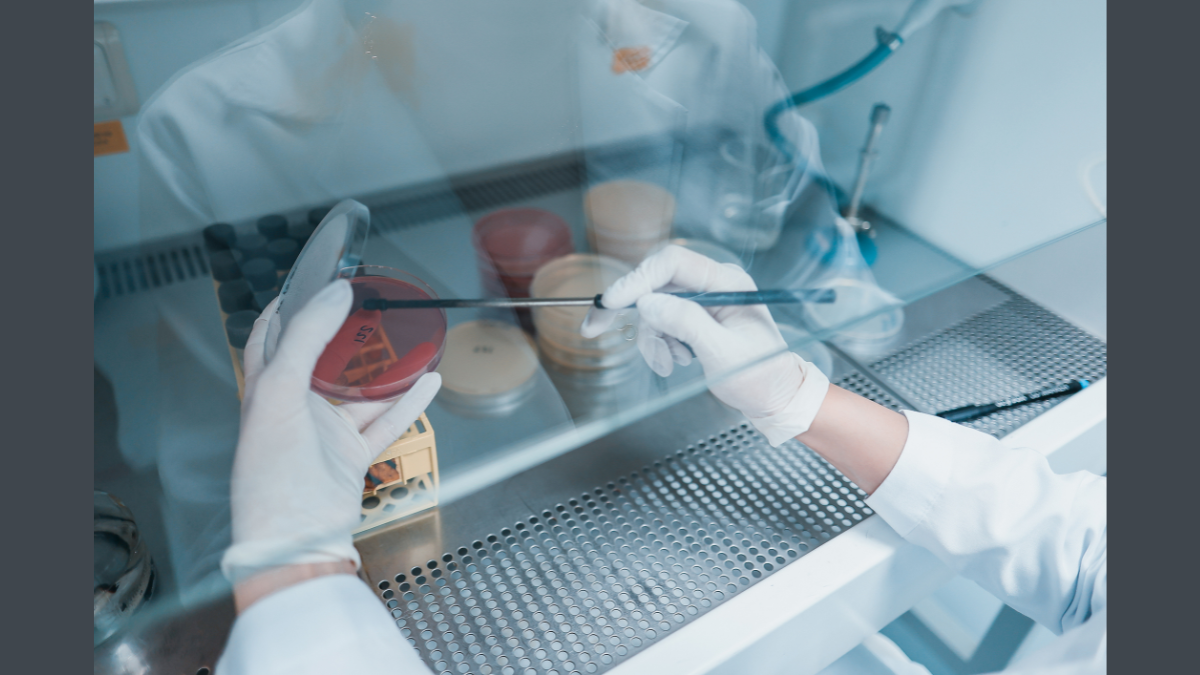

Expert opinion: Combating antimicrobial resistance to safeguard the food chain
Professor Roberto La Ragione, Professor of Veterinary Microbiology and Pathology, School of Veterinary Medicine, and Interim Pro-Vice-Chancellor and Executive Dean for the Faculty of Health and Medical Sciences at the University of Surrey, says:
Antimicrobial resistance (AMR) is a major global human, animal and environmental issue that requires an urgent coordinated “One Health, One Medicine” approach. Antimicrobial resistance is a complex issue that is driven by a variety of interconnected factors and thus can be challenging to control.
Antimicrobial resistance occurs when microorganisms (e.g. fungi, bacteria, viruses, and parasites) adapt and or evolve to resist the effects of an antimicrobial treatment, such as an antibiotic. AMR organisms can spread between animals and humans (including from humans to animals), and infections caused by AMR organisms can be harder to treat, increasing the risk of morbidity and mortality.
The inappropriate use of antimicrobials in humans, animals and plants contributes to the development and spread of AMR organisms through many routes. AMR organisms can be spread to humans via the food chain (Antimicrobial resistance (AMR) | Food Standards Agency) through several routes, including the following:
- Animal products such as meat, milk, eggs, etc.
- Poor hygiene practices can result in the spread of AMR organisms from one type of food to another (e.g. uncooked to cooked) or from the environment to food.
- Animal faeces that are used to fertilise farmland can result in the transfer of AMR organisms, such as vegetables and fruit, to the environment.
- Fruit, shellfish, and vegetables can become contaminated if the water or soil used to grow them harbours AMR organisms.
Addressing the public health threat posed by AMR is a national strategic priority for the UK and has resulted in the UK Government publishing the second 5-year National Action Plan for AMR (2024 to 2029), which outlines the commitments and outcomes that will enable progress towards the UK’s 20-year vision for AMR using a “One Health, One Medicine” approach.
The School of Veterinary Medicine at the University of Surrey plays a vital role in advancing our understanding of the emergence, persistence and transmission of infectious diseases and associated antimicrobial resistance. Our work is funded by organisations such as the Medical Research Council (MRC), European Union (EU), Biotechnology and Biological Sciences Research Council (BBSRC), Engineering and Physical Sciences Research Council (EPSRC), Arts and Humanities Research Council (AHRC), industry and charities, demonstrating our strength in human and animal-focused research.
Our research currently focuses on understanding the transmission dynamics of AMR and the development of intervention strategies, including novel antimicrobial compounds, vaccines, phage therapy, prebiotics, probiotics, postbiotics, the use of AI to predict and detect AMR, rapid diagnostics, and the use of virtual reality to enhance infection control in veterinary practices, thus improving antimicrobial stewardship.
Through a multidisciplinary “One Health, One Medicine” approach, we can tackle AMR in animals, humans and the environment.
Related sustainable development goals

Media Contacts
External Communications and PR team
Phone: +44 (0)1483 684380 / 688914 / 684378
Email: mediarelations@surrey.ac.uk
Out of hours: +44 (0)7773 479911
